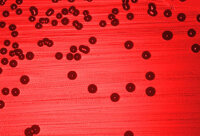
Vacuna para la meningitis por Hib

-
 La prueba final de la teoría del germen llegó cuando Pasteur fue capaz de cultivar el bacilo del ántrax en un cultivo. A pesar de que el ántrax había sido aislado por Robert Koch, quienes se oponían a sus teorías pensaban que las esporas que encontró podían haber estado confinadas en su medio de cultivo.
La prueba final de la teoría del germen llegó cuando Pasteur fue capaz de cultivar el bacilo del ántrax en un cultivo. A pesar de que el ántrax había sido aislado por Robert Koch, quienes se oponían a sus teorías pensaban que las esporas que encontró podían haber estado confinadas en su medio de cultivo. -
Los ratones fueron empleados por primera vez para la investigación genética por el biólogo francés Lucien Cuénot en 1902. Sus experimentos de hibridación demostraron que tres genes permitían la producción de un cromógeno y dos enzimas
-
Varios investigadores estudiaron las necesidades nutricionales de los mamíferos a comienzos del siglo XX. Se realizaron experimentos con las dietas de ratas y ratones jóvenes, comenzando con sencillas combinaciones dietéticas y averiguando qué más se necesitaba. Durante mucho tiempo los investigadores pensaron que los problemas de crecimiento eran resultado de los ingredientes de la dieta desnaturalizados.
-
 El sistema nervioso permite la comunicación entre los órganos del cuerpo, posibilitando que cada entidad independiente trabaje junto con las demás como parte de un sistema completo. Esto permite al organismo recibir información sobre su entorno y es fundamental para la vida animal, procesando información y enviándola de una parte del cuerpo a otra.
El sistema nervioso permite la comunicación entre los órganos del cuerpo, posibilitando que cada entidad independiente trabaje junto con las demás como parte de un sistema completo. Esto permite al organismo recibir información sobre su entorno y es fundamental para la vida animal, procesando información y enviándola de una parte del cuerpo a otra. -
El descubrimiento de la heparina, un anticoagulante naturalmente presente en los mamíferos, supuso un importante avance. La heparina fue aislada por primera vez en el hígado del perro por Jay Maclean en 1916.
-
 La primera demostración práctica de este proceso, conocido como hemodiálisis continua, la consiguió John Abel1 en 1914, utilizando conejos y perros anestesiados y membranas de diálisis fabricadas con pergamino tratado.
La primera demostración práctica de este proceso, conocido como hemodiálisis continua, la consiguió John Abel1 en 1914, utilizando conejos y perros anestesiados y membranas de diálisis fabricadas con pergamino tratado. -
El primer marcapasos cardíaco fue inventado por un ingeniero eléctrico canadiense, John Hopps, que estaba investigando los efectos del calentamiento por radiofrecuencia sobre la hipotermia en 1941.
-
 El primer trasplante de corazón con éxito en seres humanos fue realizado por el cirujano sudafricano Christiaan Barnard el 3 de diciembre de 1967, mientras que los equipos norteamericanos todavía se estaban preparando para trasladar su trabajo a los seres humanos.
El primer trasplante de corazón con éxito en seres humanos fue realizado por el cirujano sudafricano Christiaan Barnard el 3 de diciembre de 1967, mientras que los equipos norteamericanos todavía se estaban preparando para trasladar su trabajo a los seres humanos. -
La lepra es una enfermedad con una larga historia. Hay evidencias de que existió en el año 4.000 A.C en el antiguo Egipto y aparecen numerosas referencias en la Bíblia.1 Sin embargo, no fue hasta 1873 cuando Armauer Hansen estableció su causa al observar la bacteria responsable, Mycobacterium leprae, en el microscopio
-
La Haemophilus influenzae tipo B (Hib) es otra forma bacteriana de meningitis. Fue descrita por primera vez por Richard Pfeiffer en 1892 durante un brote de gripe y se pensó por error que era la causa de la gripe hasta 1933, cuando se puso de manifiesto que la gripe estaba provocada por un virus.
La Haemophilus influenzae tipo B (Hib) es otra forma bacteriana de meningitis. Fue descrita por primera vez por Richard Pfeiffer en 1892 durante un brote de gripe y se pensó por error que era la causa de la gripe hasta 1933, cuando se puso de manifiesto que la gripe estaba provocada por un virus. -
En 2002 el Consorcio para la Secuenciación del Genoma del Ratón publicó la secuencia inicial y el análisis del genoma del ratón en Nature. El Consorcio es una empresa público-privada creada en el año 2000 para acelerar la secuenciación del código.
-
 Un equipo dirigido por el profesor Paolo Macchiarini de la Universidad de Barcelona, en España, realizó el primer trasplante de un órgano completo cultivado a partir de las propias células madre de un paciente.1
Un equipo dirigido por el profesor Paolo Macchiarini de la Universidad de Barcelona, en España, realizó el primer trasplante de un órgano completo cultivado a partir de las propias células madre de un paciente.1
